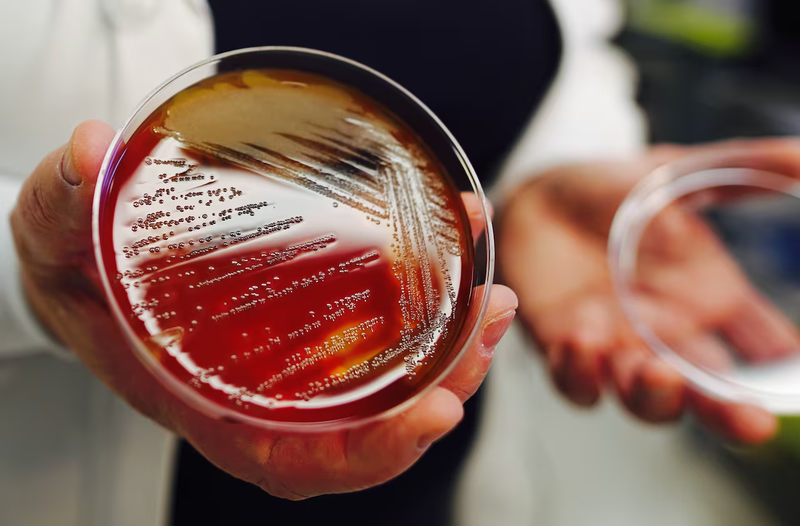
Liên cầu khuẩn nhóm B là gì? Những ảnh hưởng đối với mẹ bầu và thai nhi 4
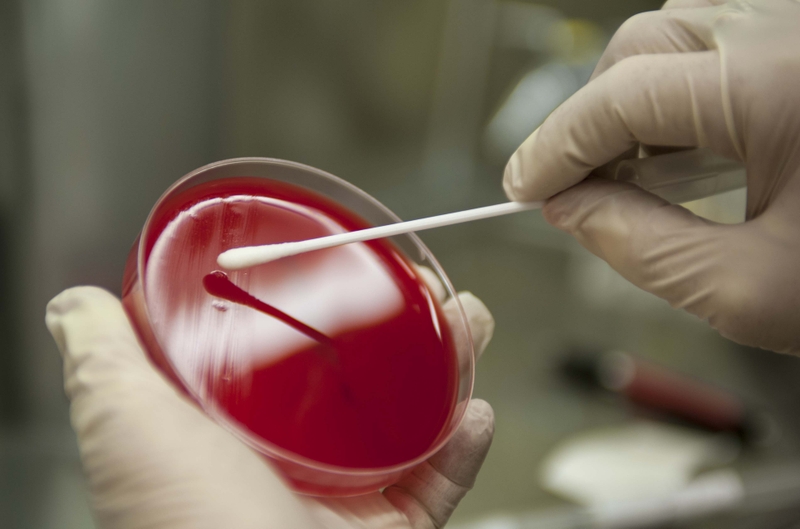
Liên cầu khuẩn nhóm B là gì? Những ảnh hưởng đối với mẹ bầu và thai nhi 5

Dược sĩ Đại học có nhiều năm kinh nghiệm trong việc tư vấn Dược phẩm và hỗ trợ giải đáp thắc mắc về Bệnh học. Hiện đang là giảng viên cho Dược sĩ tại Nhà thuốc Long Châu.
Kim Ngân
30/07/2024
Mặc định
Lớn hơn
Liên cầu khuẩn nhóm B gây ra bệnh lý nguy hiểm thường gặp ở các mẹ bầu trong tuần thai kỳ thứ 35 - 37, làm tăng nguy cơ xuất hiện nhiều biến chứng nghiêm trọng, thậm chí dẫn đến tử vong cho thai nhi.
Trước khi bắt đầu hành trình mang thai, các chị em phụ nữ cần tìm hiểu trước những căn bệnh mà mẹ bầu dễ gặp nhất để chủ động phòng ngừa, theo dõi và ngăn chặn kịp thời, vì lúc này sức khỏe người mẹ sẽ yếu đi và dễ bị vi khuẩn tấn công, đặc biệt là liên cầu khuẩn nhóm B. Chúng có nguy cơ gây ra nhiều hệ lụy khó lường trước như viêm phổi, nhiễm trùng huyết,... cho trẻ sơ sinh. Bài viết sau đây sẽ có những thông tin cụ thể đến bạn về nhóm vi khuẩn này, mọi người tham khảo ngay nhé.
Liên cầu nhóm B (GBS) là loại vi khuẩn sống ở đoạn cuối ruột non của phụ nữ khỏe mạnh chiếm từ 15 - 40% và sống ở âm đạo hoặc trực tràng phụ nữ mang thai chiếm đến 20 - 30% và không có bất kỳ biểu hiện nào, có khả năng cao lây truyền từ mẹ sang con trong quá trình chuyển dạ. Bên cạnh đó bệnh còn xuất hiện ở một số đối tượng khác như:
Riêng đối với thai phụ mắc bệnh GBS có nguy cơ cao bị nhiễm trùng đường tiết niệu, viêm nội mạc tử cung, sinh non, nhiễm trùng vết mổ,... Đặc biệt càng nguy hiểm hơn cho thai nhi khi có nguy cơ cao bị lây bệnh từ mẹ và mắc bệnh viêm màng não ở trẻ sơ sinh.
Do đó xét nghiệm liên cầu khuẩn được nhiều bác sĩ sản khoa khuyến cáo cần phải thực hiện cho mẹ bầu trước khi quá trình chuyển dạ để hạn chế tối đa khả năng lây bệnh từ mẹ sang con.

Như đã đề cập liên cầu khuẩn nhóm B thường gặp ở các chị em và mẹ bầu ở tuần thai 35 - 37, gây ra nhiều mối nguy hiểm cho cả mẹ và bé dưới đây, chúng ta cần phải chủ động thực hiện phòng ngừa.
Mẹ bầu nhiễm liên cầu khuẩn nhóm B sẽ có tỷ lệ sinh non, chuyển dạ sớm và đối mặt với nhiều mối lo khác ảnh hưởng trực tiếp đến sức khỏe sau khi sinh như nhiễm trùng ối, vỡ ối sớm,...
Ngoài ra ở một số trường hợp mắc bệnh còn được chẩn đoán nhiễm trùng tiểu, viêm đài bể thận, viêm nội mạc tử cung, viêm vú,... do vi khuẩn liên cầu không phát hiện sớm và điều trị đúng cách.
Không chỉ tác động đến sức khỏe của người mẹ, liên cầu khuẩn GBS còn đe dọa đến sự phát triển của thai nhi gây nhiễm trùng sớm và các bệnh lý khác như: Hô hấp kém, biểu hiện hạ huyết áp, tăng nguy cơ cao mắc bệnh viêm phổi, viêm màng não,... thậm chí có thể tử vong do nhiễm liên cầu khuẩn B quá sớm và gây khó khăn cho việc điều trị vì cơ thể trẻ còn quá yếu.
Không chỉ trẻ sơ sinh khi chào đời mới có nguy cơ mắc bệnh, trẻ từ 7 - 90 ngày tuổi cũng có thể bị nhiễm vi khuẩn GBS (gọi là nhiễm trùng sơ sinh muộn), vì bú sữa mẹ sau khi bị viêm tuyến vú. Giai đoạn này cũng là giai đoạn nguy hiểm khi tỷ lệ cao gây ra bệnh viêm màng não và để lại nhiều chiến chứng nguy hiểm về sau như hạn chế khả năng vận động, kém phát triển não bộ,...

Thai phụ mắc bệnh liên cầu khuẩn nhóm B sẽ không có triệu chứng rõ rệt, nên rất khó phát hiện bệnh. Ở nhiều trường hợp đến khi chuẩn bị chuyển dạ mới phát hiện nhiễm bệnh, gây khó khăn cho quá trình chăm sóc cho cả hai mẹ con.
Thực tế mẹ bầu nhiễm bệnh sẽ thường chuyển dạ sớm ở tuần thứ 35 - 37 hoặc vỡ ối sớm mà không có dấu hiệu chuyển dạ. Bên cạnh đó khi nhiễm liên cầu khuẩn B, mẹ bầu rất dễ sốt cao trên 37,8 độ C trong giai đoạn sinh nở, điều này sẽ làm ảnh hưởng ít nhiều đến việc đỡ đẻ vì bác sĩ phải cực kỳ lưu ý để hạn chế nguy cơ lây lan sang trẻ sơ sinh. Một số dấu hiệu khác cho thấy thai phụ bị nhiễm bệnh gồm:
Nếu các chị em đã từng nhiễm GBS trước đó hoặc trong những lần mang thai trước, có tỷ lệ cao nhiễm bệnh. Cách tốt nhất trong suốt hành trình mang thai, các mẹ cần phải chủ động theo dõi, thực hiện xét nghiệm nước tiểu để phát hiện vi khuẩn và kịp thời điều trị thích hợp, đảm bảo sức khỏe cho cả mẹ và bé.

Cho đến hiện tại, bệnh liên cầu khuẩn nhóm B vẫn chưa có vacxin phòng ngừa, vì thế chỉ có 2 cách tốt nhất để tránh lây nhiễm bệnh từ mẹ sang con trong quá trình mang thai và sau khi chuyển dạ.
Theo khuyến cáo từ Đại học Sản phụ khoa và Đại học Y tá - Hộ sinh tại Hoa Kỳ, phụ nữ mang thai nên thực hiện xét nghiệm vi khuẩn GBS trong giai đoạn tuần thai thứ 36 - 37.
Quá trình xét nghiệm thực hiện đơn giản, khi chỉ cần dùng tăm bông lấy mẫu từ âm đạo và trực tràng, không gây tổn thương cho cả mẹ và bé. Đối với trường hợp dương tính mà không có triệu chứng, không có nghĩa mẹ và bé đang nhiễm bệnh mà kết quả thể hiện mẹ có tỷ lệ cao lây bệnh sang thai nhi khi chào đời.
Lúc này các bác sĩ sẽ cân nhắc chỉ định áp dụng biện pháp thứ hai dưới đây để phòng ngừa trẻ sơ sinh bị lây truyền bệnh trong quá trình mẹ chuyển dạ.
Cách hạn chế tối đa nguy cơ trẻ nhiễm bệnh là tiêm một loại kháng sinh qua tĩnh mạch ở các mẹ bầu trong quá trình sinh nở, gọi là beta-lactam (gồm penicillin và ampicillin). Trong đó, penicillin thường được sử dụng để ngừa bệnh khởi phát sớm ở trẻ sơ sinh.
Thực tế cho thấy việc sử dụng thuốc kháng sinh để ngừa bệnh liên cầu khuẩn nhóm B ở trẻ sơ sinh khi chào đời từ người mẹ dương tính với bệnh rất hiệu quả, không cần điều trị nếu mẹ đã được tiêm kháng sinh trong quá trình chuyển dạ.
Lưu ý kháng sinh sẽ không được tiêm trước khi chuyển dạ vì có thể làm vi khuẩn phát triển nhanh chóng. Hơn nữa kháng sinh có thể ngăn ngừa bệnh liên cầu khuẩn khởi phát sớm ở trẻ nhưng không thể ngừa bệnh khởi phát trễ. Do đó cần theo dõi trẻ kỹ trong tuần đầu tiên, nếu xuất hiện các dấu hiệu như buồn ngủ, ăn kém, thở nhanh, tăng thân nhiệt thì cần phải đưa trẻ đến các cơ sở y tế gần nhất để được chẩn đoán và điều trị kịp thời.
Như đã nói ở trên, khi bắt đầu quy trình xét nghiệm, bác sĩ sẽ dùng tăm bông hoặc miếng gạc lấy lượng dịch ở âm đạo tách riêng với mẫu dịch ở trực tràng để thực hiện xét nghiệm. Ngoài ra mẫu dịch cũng có thể lấy từ nước tiểu trong quá trình kiểm tra tiền sản.
Sau khi có mẫu dịch sẽ được chuyển đến phòng xét nghiệm để phân tích, nếu không được chuyển đi ngay vì bất kỳ lý do nào đó, mẫu dịch sẽ được lưu lại trong ngăn mát tủ lạnh không quá 2 tiếng và kết quả xét nghiệm sẽ có sau khoảng 2 - 3 ngày.
Hy vọng qua bài viết mọi người sẽ hiểu được mức độ nguy hiểm của liên cầu khuẩn nhóm B đe dọa trực tiếp đến mẹ bầu và trẻ sơ sinh như thế nào, đặc biệt trong tuần thai từ 35 - 37. Từ đó có biện pháp chủ động theo dõi định kỳ, xét nghiệm tầm soát sớm để hạn chế tối đa nguy cơ lây nhiễm cho trẻ sơ sinh.
Xem thêm:
Dược sĩ Đại họcNguyễn Mỹ Huyền
Dược sĩ Đại học có nhiều năm kinh nghiệm trong việc tư vấn Dược phẩm và hỗ trợ giải đáp thắc mắc về Bệnh học. Hiện đang là giảng viên cho Dược sĩ tại Nhà thuốc Long Châu.